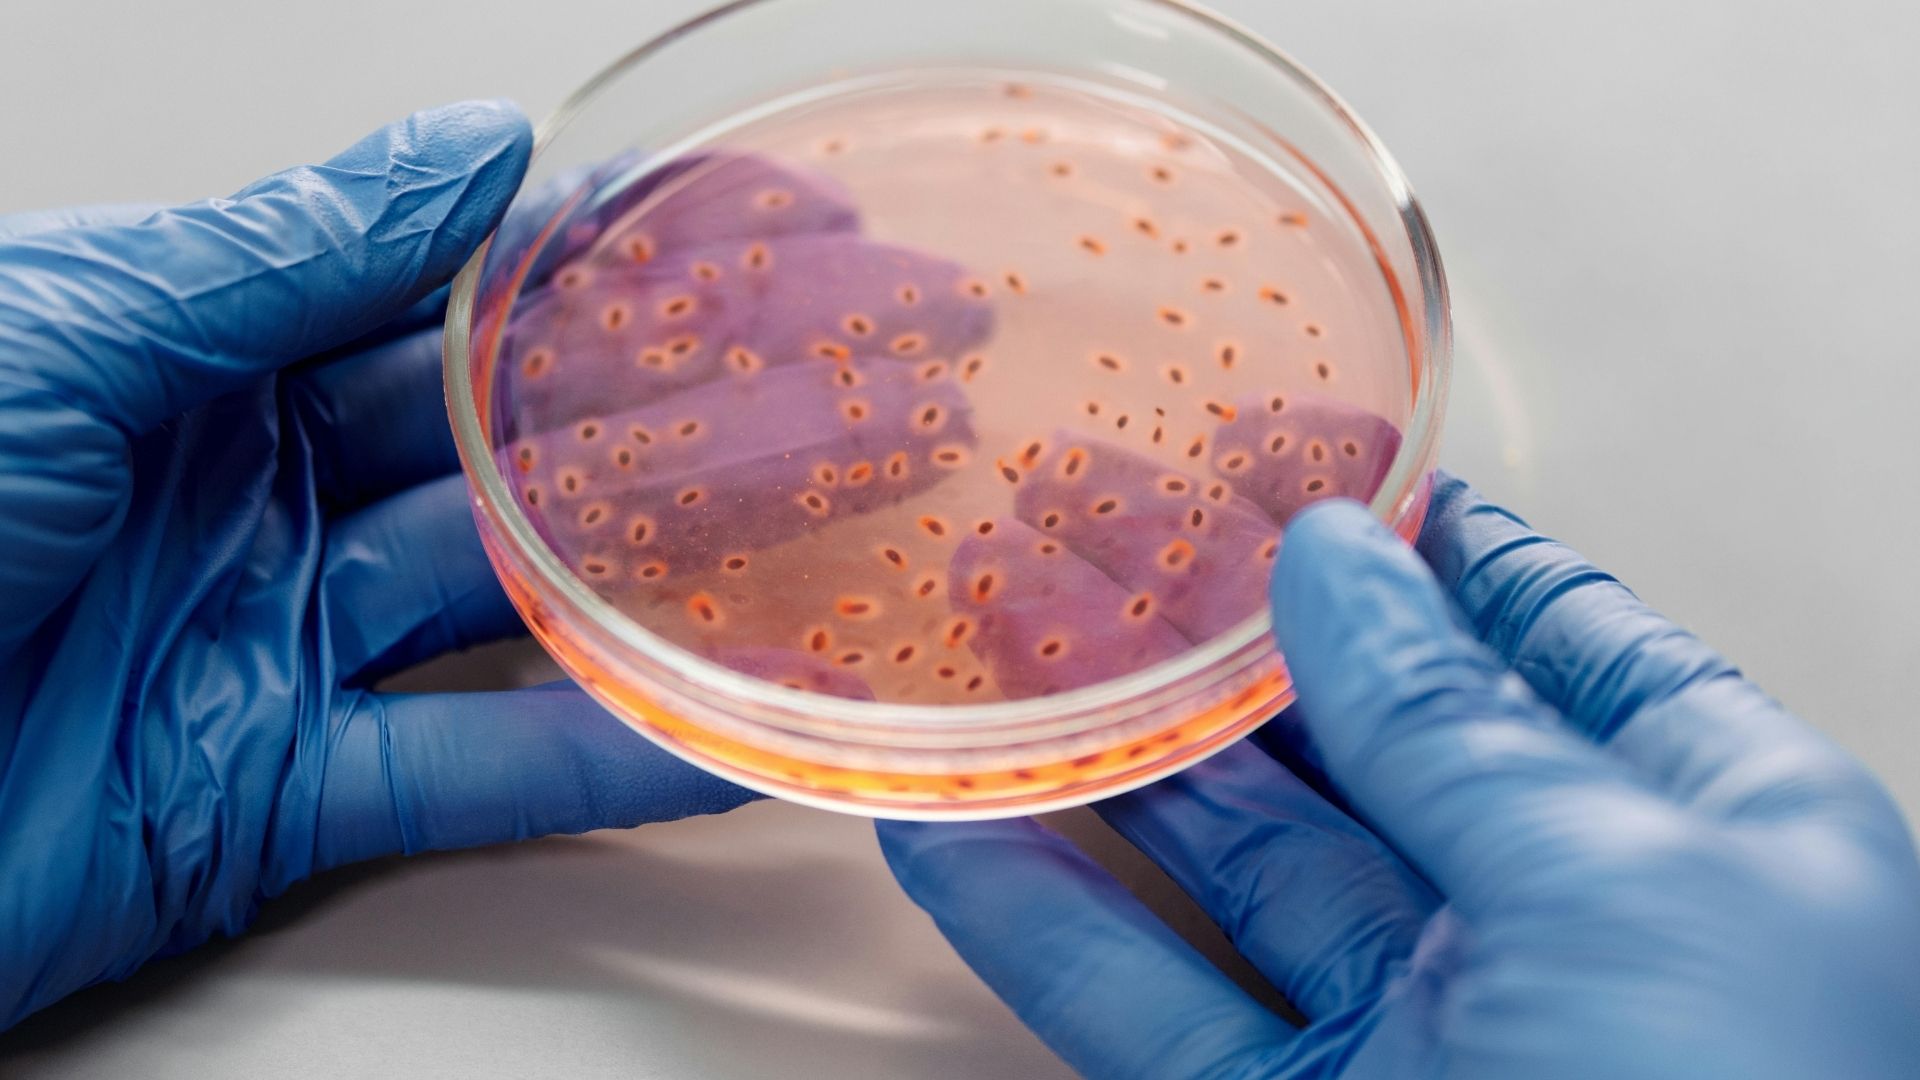
Vi khuẩn Helicobacter pylori là nguyên nhân phổ biến gây bệnh

Tìm hiểu chung về viêm niêm mạc dạ dày
Niêm mạc dạ dày là lớp tế bào lót bên trong thành dạ dày, có vai trò tiết chất nhầy, enzyme và acid để hỗ trợ tiêu hóa. Khi lớp này bị kích thích kéo dài bởi các yếu tố như vi khuẩn, hóa chất, hoặc stress, phản ứng viêm sẽ xảy ra. Viêm niêm mạc dạ dày là tình trạng lớp niêm mạc bị tổn thương, có thể kèm theo phù nề, sung huyết, hoặc mất tế bào tuyến.
Tùy theo vị trí tổn thương, bệnh có thể khu trú ở hang vị, thân vị hoặc lan tỏa toàn bộ dạ dày. Một số trường hợp có thể kèm theo dị sản ruột hoặc loạn sản - những dấu hiệu cảnh báo nguy cơ ung thư hóa.
Triệu chứng viêm niêm mạc dạ dày
Những dấu hiệu và triệu chứng của viêm niêm mạc dạ dày
Viêm niêm mạc dạ dày có thể biểu hiện bằng nhiều triệu chứng khác nhau, tùy thuộc vào mức độ tổn thương và nguyên nhân gây bệnh. Một số người chỉ có biểu hiện nhẹ, trong khi những trường hợp nặng có thể ảnh hưởng rõ rệt đến sinh hoạt hàng ngày.
Dưới đây là các biểu hiện lâm sàng thường gặp:
- Cảm giác đau tức vùng bụng trên, đặc biệt sau khi ăn thức ăn nhiều dầu mỡ hoặc khi đói.
- Buồn nôn nhẹ, đôi khi kèm theo nôn, nhất là vào buổi sáng hoặc sau khi ăn quá no.
- Cảm giác chướng bụng, đầy hơi, khó tiêu, đặc biệt sau các bữa ăn lớn.
- Thay đổi khẩu vị, ăn không ngon, dễ ngán, đặc biệt với các món nhiều gia vị.
- Ợ hơi, ợ nóng, có thể kèm theo cảm giác trào ngược dịch vị lên cổ họng.

Biến chứng có thể gặp khi mắc viêm niêm mạc dạ dày
Viêm niêm mạc dạ dày nếu kéo dài mà không được điều trị đúng cách có thể gây ra nhiều hậu quả nghiêm trọng. Những tổn thương ban đầu tưởng chừng đơn giản có thể tiến triển thành các rối loạn phức tạp, ảnh hưởng đến toàn bộ hệ tiêu hóa.
Dưới đây là các biến chứng có thể xảy ra:
- Hình thành ổ loét: Khi lớp bảo vệ niêm mạc bị phá vỡ, acid dịch vị có thể ăn mòn sâu vào thành dạ dày.
- Chảy máu tiêu hóa: Các mao mạch bị tổn thương có thể vỡ, gây xuất huyết âm thầm hoặc cấp tính.
- Thiếu hụt dinh dưỡng: Niêm mạc bị viêm làm giảm khả năng hấp thu các khoáng chất và vitamin thiết yếu.
Khi nào cần gặp bác sĩ?
Không phải mọi cơn đau bụng đều là dấu hiệu của bệnh lý nghiêm trọng, nhưng viêm niêm mạc dạ dày thường không tự khỏi nếu không có can thiệp y tế. Việc trì hoãn thăm khám có thể khiến tổn thương lan rộng và khó phục hồi.
Dưới đây là những tình huống nên chủ động đến cơ sở y tế:
- Cảm giác đau vùng bụng trên xuất hiện lặp đi lặp lại, đặc biệt sau bữa ăn hoặc khi đói.
- Buồn nôn kéo dài, không rõ nguyên nhân, kèm theo chán ăn hoặc sụt cân.
- Thường xuyên ợ nóng, ợ hơi, có cảm giác dịch vị trào ngược lên cổ họng.
- Mệt mỏi không giải thích được, nghi ngờ thiếu máu hoặc suy dinh dưỡng.
- Có tiền sử sử dụng thuốc giảm đau hoặc kháng viêm dài ngày mà không có hướng dẫn của bác sĩ.

Nguyên nhân gây viêm niêm mạc dạ dày
Viêm niêm mạc dạ dày không phải là một bệnh lý đơn nguyên. Quá trình hình thành tổn thương thường bắt nguồn từ sự kết hợp của nhiều yếu tố nội sinh và ngoại sinh, tác động trực tiếp hoặc gián tiếp lên lớp niêm mạc lót trong dạ dày.
Dưới đây là các nguyên nhân phổ biến:
- Vi khuẩn Helicobacter pylori: Loại vi khuẩn này có khả năng sống trong môi trường acid, gây phá vỡ lớp chất nhầy bảo vệ niêm mạc.
- Sử dụng thuốc không đúng chỉ định: Một số loại thuốc giảm đau, kháng viêm hoặc corticoid có thể gây kích ứng niêm mạc.
- Tác động từ hóa chất: Tiếp xúc với kim loại nặng, thuốc trừ sâu hoặc các chất độc hại qua thực phẩm.
Nguy cơ mắc bệnh viêm niêm mạc dạ dày
Những ai có nguy cơ mắc bệnh viêm niêm mạc dạ dày?
Không phải ai cũng có nguy cơ mắc viêm niêm mạc dạ dày như nhau. Một số nhóm người có đặc điểm sinh học hoặc thói quen sống khiến họ trở thành đối tượng dễ bị tổn thương hơn cả.
Dưới đây là những nhóm người thường gặp bệnh:
- Người thường xuyên chịu áp lực công việc, dễ rơi vào trạng thái căng thẳng kéo dài.
- Cá nhân có thói quen ăn uống không điều độ, bỏ bữa sáng hoặc ăn khuya thường xuyên.
- Người từng điều trị dài ngày bằng thuốc giảm đau, đặc biệt là nhóm không steroid.
- Người có tiền sử mắc các bệnh lý liên quan đến gan, tụy hoặc đường mật, làm ảnh hưởng đến chức năng tiêu hóa.
- Người cao tuổi, do khả năng tái tạo tế bào niêm mạc giảm theo thời gian.
Yếu tố làm tăng nguy cơ mắc bệnh viêm niêm mạc dạ dày
Không chỉ những nguyên nhân trực tiếp gây bệnh, mà các yếu tố làm tăng mức độ tổn thương hoặc kéo dài quá trình viêm cũng cần được nhận diện rõ. Những yếu tố này thường âm thầm, khó kiểm soát, nhưng lại đóng vai trò quan trọng trong việc khiến bệnh trở nên dai dẳng.
Dưới đây là các yếu tố nguy cơ thúc đẩy bệnh tiến triển:
- Thường xuyên ăn thực phẩm có tính acid cao như giấm, trái cây chua hoặc nước ngọt có gas.
- Thói quen nằm ngay sau khi ăn, khiến dịch vị dễ trào ngược và gây kích ứng niêm mạc.
- Sử dụng đồ uống có chứa caffeine hoặc theobromine với tần suất cao, làm tăng tiết acid dịch vị.
- Môi trường sống ô nhiễm, tiếp xúc với hóa chất công nghiệp hoặc khói bụi trong thời gian dài.
- Lạm dụng thực phẩm chức năng không rõ nguồn gốc, đặc biệt các loại hỗ trợ giảm cân hoặc tăng cơ.

Phương pháp chẩn đoán và điều trị viêm niêm mạc dạ dày
Phương pháp xét nghiệm và chẩn đoán viêm niêm mạc dạ dày
Để xác định chính xác tình trạng viêm niêm mạc dạ dày, bác sĩ cần kết hợp nhiều kỹ thuật lâm sàng và cận lâm sàng. Việc chẩn đoán không chỉ nhằm xác định vị trí tổn thương mà còn đánh giá mức độ ảnh hưởng đến chức năng tiêu hóa.
Dưới đây là các phương pháp thường được sử dụng:
- Khám lâm sàng: Đánh giá triệu chứng, tiền sử bệnh lý và thói quen sinh hoạt của người bệnh.
- Nội soi dạ dày: Quan sát trực tiếp lớp niêm mạc, phát hiện vùng viêm, xung huyết hoặc tổn thương bề mặt.
- Sinh thiết mô: Lấy mẫu niêm mạc để phân tích dưới kính hiển vi, xác định mức độ viêm và loại trừ nguy cơ ác tính.
- Xét nghiệm máu: Kiểm tra các chỉ số viêm, tình trạng thiếu máu hoặc rối loạn miễn dịch.
- Test hơi thở hoặc xét nghiệm phân: Phát hiện sự hiện diện của vi khuẩn gây viêm.
Phương pháp điều trị viêm niêm mạc dạ dày
Về điều trị, bác sĩ sẽ cá thể hóa phác đồ tùy theo nguyên nhân và mức độ tổn thương:
- Dùng thuốc kháng acid hoặc ức chế tiết dịch vị để giảm kích ứng.
- Loại bỏ yếu tố gây viêm như vi khuẩn, thuốc hoặc thực phẩm không phù hợp.
- Hướng dẫn thay đổi lối sống và chế độ ăn uống.
- Theo dõi định kỳ để đánh giá đáp ứng điều trị và ngăn ngừa tái phát.
Việc phối hợp chặt chẽ giữa người bệnh và bác sĩ chuyên khoa là yếu tố quyết định hiệu quả điều trị lâu dài.
Chế độ sinh hoạt và phòng ngừa viêm niêm mạc dạ dày
Những thói quen sinh hoạt có thể giúp bạn hạn chế diễn tiến của viêm niêm mạc dạ dày
Chế độ sinh hoạt:
Lối sống hàng ngày có ảnh hưởng trực tiếp đến quá trình phục hồi của lớp niêm mạc dạ dày. Những điều tưởng chừng nhỏ nhặt như giờ giấc ăn uống hay cách nghỉ ngơi đều góp phần quyết định hiệu quả điều trị.
Dưới đây là những thói quen sinh hoạt nên duy trì:
- Ăn uống đúng thời điểm, tránh để bụng quá đói hoặc ăn quá muộn vào ban đêm.
- Chia nhỏ khẩu phần trong ngày, giúp giảm áp lực lên hệ tiêu hóa sau mỗi bữa ăn.
- Dành thời gian nghỉ ngơi sau ăn, không vận động mạnh hoặc nằm ngay sau khi ăn.
- Tăng cường vận động nhẹ nhàng như đi bộ, tập thở sâu hoặc các bài giãn cơ đơn giản.
- Không tự ý dùng thuốc khi chưa có chỉ định, đặc biệt là các loại giảm đau hoặc hỗ trợ tiêu hóa.
Chế độ dinh dưỡng:
Thực phẩm không chỉ là nguồn cung cấp năng lượng mà còn là yếu tố quyết định tốc độ lành tổn thương của niêm mạc dạ dày. Một chế độ ăn hợp lý giúp giảm kích ứng, cân bằng môi trường acid và thúc đẩy quá trình tái tạo tế bào.
Dưới đây là các nguyên tắc dinh dưỡng nên áp dụng:
- Hạn chế gia vị cay, tiêu, tỏi sống và các loại nước sốt đậm đặc.
- Bổ sung protein từ nguồn ít béo như cá hấp, thịt gà bỏ da hoặc đậu phụ.
- Tăng cường rau củ luộc, hấp để cung cấp chất xơ mà không gây cọ xát niêm mạc.
- Không dùng thực phẩm chế biến sẵn, đồ chiên rán hoặc đóng hộp có chất bảo quản.

Phương pháp phòng ngừa viêm niêm mạc dạ dày
Viêm niêm mạc dạ dày là bệnh lý có thể phòng tránh nếu người bệnh chủ động điều chỉnh lối sống và kiểm soát các yếu tố nguy cơ. Việc dự phòng không chỉ giúp giảm tỷ lệ mắc bệnh mà còn hạn chế tái phát sau điều trị.
Dưới đây là các biện pháp phòng ngừa nên áp dụng:
- Ưu tiên thực phẩm tươi, sạch, hạn chế đồ ăn nhanh, thực phẩm đóng gói hoặc chứa phụ gia tổng hợp.
- Không sử dụng thuốc giảm đau hoặc kháng viêm kéo dài nếu không có chỉ định rõ ràng từ bác sĩ.
- Tăng cường vận động thể chất vừa phải, giúp cải thiện tuần hoàn máu đến hệ tiêu hóa.
- Khám sức khỏe định kỳ, đặc biệt khi có tiền sử bệnh lý tiêu hóa hoặc triệu chứng kéo dài không rõ nguyên nhân.

Viêm niêm mạc dạ dày là bệnh lý tiêu hóa phổ biến nhưng dễ bị xem nhẹ trong giai đoạn đầu. Việc chủ động nhận diện triệu chứng, kiểm soát nguyên nhân và duy trì thói quen sống lành mạnh đóng vai trò thiết yếu trong phòng ngừa và điều trị. Nội soi định kỳ, kết hợp với chế độ ăn uống hợp lý và sinh hoạt khoa học, sẽ giúp người bệnh bảo vệ niêm mạc dạ dày và duy trì sức khỏe tiêu hóa ổn định lâu dài.
:format(webp)/Desktop_da87817305.png)
:format(webp)/Mobile_1_0b0c1a773a.png)
:format(webp)/viem_niem_mac_da_day_065ce8ad75.png)
/benh_a_z_viem_niem_mac_0_b084a20496.jpg)
/benh_a_z_viem_da_day_man_tinh_c08e1087cd.jpg)
/da_day_nam_o_dau_dau_hieu_canh_bao_cac_benh_ly_o_da_day_0_5425fece5b.png)
/hep_phi_dai_mon_vi_o_tre_so_sinh_la_gi_nguyen_nhan_cach_dieu_tri_va_phong_ngua_1_5df8b82050.jpg)
/hep_mon_vi_trieu_chung_nguyen_nhan_va_cach_dieu_tri_2_3d37cb9bb2.jpg)